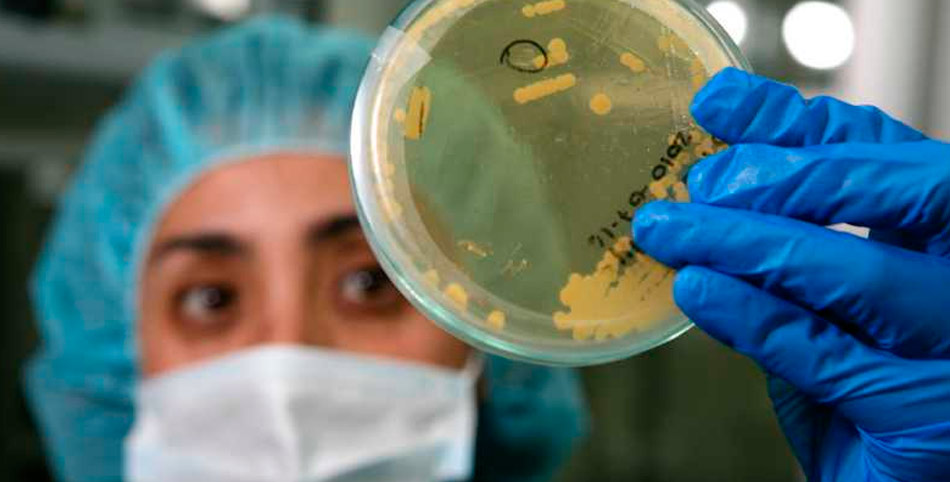
sadfadsasd

Carros sin conductor
Los coches sin conductor podrían tardar todavía algunos años para hacerse realidad, pero en 2018 el nivel de automatización de los coches se acelerará rápidamente.
Vamos a experimentar algo más cercano a un coche sin conductor por primera vez y debatir sobre su posible impacto en nuestras vidas, señala el Museo de Ciencias de Londres.
Tal vez ya tengas un coche con algunas de esas capacidades. Como un control de velocidad crucero para los largos viajes o asistencia para estacionar en un espacio pequeño.
En 2018 también seremos testigos del lanzamiento de automóviles con mayor nivel de autonomía. Audi y Tesla podrían lanzar coches que se podrían conducir solos en condiciones de caminos sin obstáculos y a una baja velocidad.
Pero este nivel de automatización todavía depende de la intervención
Humana cuando las condiciones cambian o se presentan problemas.
Direct Line, una compañía de seguros de autos en Gran Bretaña, ofrecerá un descuento para quienes usen la tecnología de autopiloto en algunos modelos de Tesla. Su intención es recopilar información sobre el uso de esa tecnología.
Si quieres abordar un autobús sin conductor, puedes intentarlo en Bavaria, Alemania; en Las Vegas, en EE.UU. o Lyon, Francia.
Aunque en 2018 veremos mucha más tecnología, el camino hacia la conducción automática completa todavía tiene algunos baches. El programa “drive me” (condúceme), de Volvo, que planeaba pruebas de manejo sin conductor fue retrasado hasta 2021.
Ingeniería genética
La edición del genoma tiene la capacidad de alterar radicalmente la forma en que tratamos las enfermedades, pero tiene algunos riesgos.
En esencia, el proceso nos permite reemplazar un gen defectuoso con uno sano, o incluso editar el gen para hacer que se comporte de manera diferente.
Es un “impacto de la ciencia biológica que tiene ramificaciones tremendas y potenciales”, asegura Sir John Skehel, de la Royal Society de Londres.
El alcance de tratamientos para condiciones heredadas genéticamente es claro. Si los científicos pueden editar los genes para quitarles errores heredados, entonces pueden detener el desarrollo de esas condiciones.
Pero ese descubrimiento tiene su lado malo. Por ejemplo, si editáramos genes con fines cosméticos, podríamos causar daños imprevistos.
La ciencia puede enseñar a la humanidad de lo que son capaces las tecnologías genéticas, pero depende de nosotros cómo queremos usarlas.
De cualquier forma, el aumento en la edición del genoma es uno de los avances más significativos en las ciencias biológicas y puede impactar millones de vidas.
Epidemias y lucha contra la resistencia a los antibióticos
En 2018 se cumplirá el centenario de la pandemia de la gripe española, que mató al menos a 50 millones de personas.
La ciencia y la medicina han visto muchas increíbles innovaciones y descubrimientos para mejorar la salud durante el siglo pasado.
Pero en 2018 la amenaza de enfermedades que se pueden propagar por todo el mundo afectando a millones de personas nunca había sido tan grande, afirma Wellcome, un centro de investigación biomédica con sede en Londres.
Las epidemias como el ébola y el zika han mostrado las significativas amenazas que representan los brotes de enfermedades contagiosas.
2018 será un año importante para continuar los esfuerzos para protegernos mejor y asegurar que todos los países pueden actuar rápido para contener brotes de infecciones mortales y prevenir emergencias de salud.
Esto incluye trabajar en el desarrollo de nuevas vacunas.
Muchas de las epidemias que tienen el mayor peligro para la humanidad podrían ser prevenidas con vacunas, pero muy pocas vacunas se han desarrollado contra ellas.
2018 será un año crítico para continuar los esfuerzos globales para afrontar otros problemas urgentes de salud global: las superbacterias.
Los antibióticos han sido una parte vital de la medicina por más de 70 años. Sin embargo, hay un creciente número de superbacterias, o infecciones resistentes a las drogas, que no pueden ser tratadas por los antibióticos actuales.
En el mundo esas infecciones ya matan unas 700.000 personas al año. Si no se toman acciones efectivas este número seguirá creciendo. Además, las infecciones que ya se pueden tratar y las cirugías de rutina —como reemplazos de cadera y cesáreas— se podrían volver potencialmente fatales.
Los siguientes 12 meses van a ser críticos en los esfuerzos para desarrollar nuevos antibióticos y tratamientos innovadores para protegernos de las superbacterias.
También para detener el uso excesivo y mal uso de los antibióticos existentes y la investigación que ayude a entender cómo se extiende la resistencia a ellos.